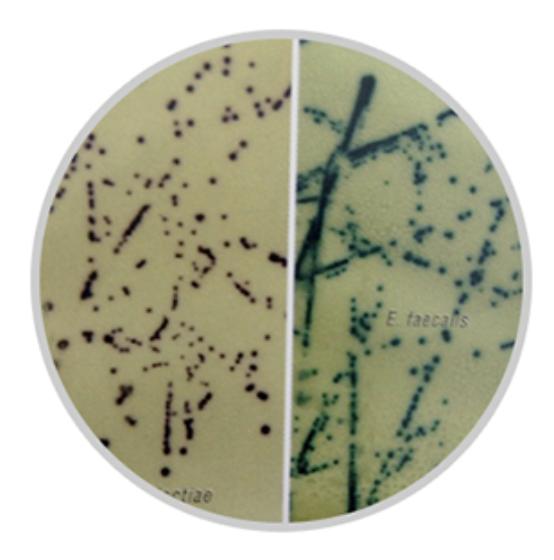
b族链球菌培养及鉴定阳性,b群链球菌培养及检测

B族链球菌显色培养基(第二代)
HiCrome Strep B Selective Agar Base,Modified

原理
B族链球菌感染是引起新生儿疾病和死亡的主要原因。 B族链球菌也可引起孕妇、老年人的严重疾病和成为并发症。B族链球菌通常位于女性阴道和男女直肠内【1】。在新生儿中,B组链球菌常引起败血症、脑膜炎和肺炎。在成年人,B族链球菌偶尔会引起严重的血液感染、尿路感染、皮肤感染和肺炎,尤其是免疫较弱的人群。母亲的生殖道感染与婴儿感染和新生儿疾病风险存在关联【2】。
样本采集通常在怀孕35~37周拭子采集阴道和直肠来完成。然后将拭子接种到B族链球菌选择性显色琼脂上。传统方法是通过Todd Hewitt肉汤(含黏菌素和萘啶酸)增菌,再传代到血平板上完成,以达到最大回收率【3】,【4】。
培养基中的特别蛋白胨和酵母粉提供氮源和碳源化合物、长链氨基酸、维生素和其他链球菌生长必需的营养。培养基中的显色底物被B族链球菌裂解,产生紫色菌落。其他链球菌产生蓝色或蓝绿色菌落,伴随黄色背景(糖发酵后酚红显色)。选择性*制剂抑**用于抑制其他微生物。
培养基成分

配制
36.83g重悬于1000ml蒸馏水。加热至沸腾。请勿高压灭菌。冷却至45-50°C,无菌加入1管复溶的选择性添加剂(货号:FD273)。混匀并倾注平板。制备好的培养基为红色。
培养反应
加入添加剂(货号:FD273)后,培养35-37°C,24-48小时

存储条件
2-8°C
参考文献
1. Anthony BF, Okada DM, Hobel CJ. Epidemiology of group B Streptoccoccus: longitudinal observations during pegnancy. J.Infect Dis 1978; 137:524-30.
2. Murray P.R. , Baron J.H., Manual of Clinical Microbiology Murray P. R., Baron J. H., Pfaller M. A., Jorgensen J. H. and Yolken R. H., (Eds.), 2003, Manual of Clinical Microbiology, 8th Ed., American Society for Microbiology, Washington, D.C
3. Prevention of perinatal group B Streptococcal disease: a public health perspective . Centres for Disease control and Prevention. MMWR Recomm Rep 1996; 51:1-22
4. NHS Processing swabs for Group B Streptococcal carriage Issue no.2.1,2006